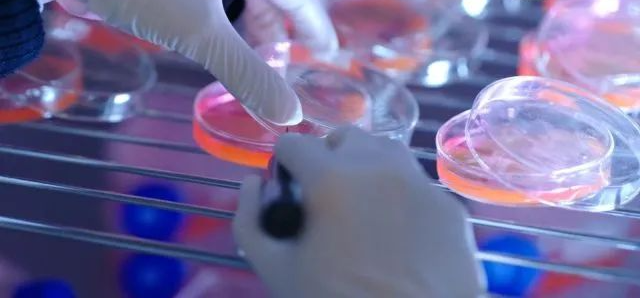

本文募格学术撰写。参考资料:知乎、微博、豆瓣、腾讯视频等。
前段时间,一则热搜「怎么没人写硕博士偶像剧」冲上榜2。在现在各行各业都有偶像剧渗透的大环境下,作为“智性恋”的主体,硕博科研领域居然没人开发??
有人一语道出精髓,不是没人写,就是咱们硕博啊,如果按照现实来拍,大概只能拍下面这种偶像剧。

对不起,早8晚11去实验室,是我不配甜甜的爱情 。
。

不过小募发现,还真不是没人写硕博士的偶像剧,不光有人写,甚至有些剧已经悄咪咪播出了,剧本里包括但不限于“抢科研成果、做科研实验、举报导师造假”等刺激情节。
但是看完之后,只能说 “拍的很好,下回不许再拍了” .....
.....
国产电视剧里的科研竟是这么做的
要说为什么大家喜欢看社会不同群体的电视剧,除了看甜甜的爱情,最主要的,也能通过电视剧中主角的日常生活,来走近这个群体,了解这个群体。
这么一听,这是打破刻板印象,让大家认识科研人员的好机会啊!
但没想到,国产电视剧的科研,竟是这样的...

图片来源:豆瓣
根据豆瓣的介绍,该剧讲的是在某项目实验室里,男主的到来是为了夺走女主的科研成果,但女主对事业的执着打动了男主,最终两人一起完成了研究,为国争光。

一上来剧情就这么炸裂,细看电视剧,发现更炸裂的还在后面。
在剧中,女主做实验时,打碎了玻璃培养皿,但她选择了用手捡起来...
用....手....捡...

(请忽略这恨天高的高跟鞋)
科研人员需要查资料了,怎么查?,两人哐哐开始翻书...

sci -hub:怎么?是我站的不够高是吗?
还有做实验时,是开着盖子培养细胞的...
细胞:谢谢了,我不想活。
当然了,只是一部电视剧是这样演的也就罢了,比较可惜的是,打着科研旗号的电视剧,大多数都不太在意科研细节。
再看看这部,从片名首先点题,这是要和科研沾边的选题。

剧情同样比较炸裂,女主的答辩因为男主的搅局最后以失败告终,女主不得不独自面对延毕的悲惨下场,在她郁闷的时间里,男主陪伴在她身边,给了她很多启发,让她去发掘了生命的更多可能。

嗯....答辩延毕....嗯....怎么说呢....。你都让我延毕了我还能和你有爱情线 ?
?
再来看看科研部分,师兄啊,实验室里吃饭,多少有点违反实验室规定了。

实验对象是,隔壁城市动物园的一只猕猴。
动物伦理委员会:这很难评

还有,你们是盖上培养皿养细胞会被扣钱是吗?

大半夜的,小反派想陷害别人往别人的细胞里加dmso,但是这不戴手套直接上,属实是杀人八百自损一千五。

还有最近播了几集被骂下架的这部《我的中国芯》。

看看海报上的叙述,科研之路,孤勇前行!
是不是感觉燃起来了!
但是哈,承担了国家芯片项目的科研实验室,长这样。

在实验的时候,普通人和科研人员一起,在实验室里看实验,结果哈,实验还爆炸了.....

咱们就是说,但凡查查资料看人家科研人员都是咋穿衣服咋实验的也行啊。

ASML披露的图片
只能说,搞科研,不是儿戏!
科研安全普及度
还需努力
也许很多人会觉得,电视剧要进行美化,这么演也无所谓。
但是,大家往往忽略了宣传在潜意识里的重要性。
有时候还真不是网友非要挑刺,比如不穿防护服,不戴手套做实验等等。
不听劝,真会出大事...
曾经在b站上有位化学up主,据称是一名在家自建实验的初中生,家中储备有不少危险的化学品,且喜欢进行一些存在风险的化学实验整活,也有不少人在评论区提醒,比如家里没有通风橱、防护不到位等问题。

视频可以看到,做实验的时候都是徒手无防护,后面突然视频断更了,有人说是因为防护不足在使用氢氟酸时发生了意外,并因为氢氟酸导致的骨溶解而离世。
不过,官方后面又出面解释说,具体是否离世无法佐证,留下的,只有一个3年过去了至今未更新的b站账号。
还有像是在实验室吃东西。
20年代时,曾有一名28岁化学家H. W. 使用五氯化磷,盐酸,乙酰氯和重氮甲烷做了一些合成反应。随后在12月2日,他将反应的剂量扩大了许多,重新做了一遍。
为了不离开他正在进行中的蒸馏过程,他就在实验室里把他的午饭(汉堡)吃掉了。尽管H. W. 是在通风橱内进行的反应,但实验过程中他仍可能在不经意间吸入了实验产生的气体。不仅如此,因为重氮甲烷良好的脂溶性,那个很油的汉堡在溶解重氮甲烷这一过程中起到了一定的作用。

在随后的几天内,H. W. 发展出了一系列类似于普通感冒/上呼吸道感染的症状。因为当时医疗水平有限,缺乏对一些药物的认识,时隔4日才确诊原因开始治疗,但H. W. 仍在几天内不治身亡。
虽然都是小细节,但若让别人觉得,实验就该这样做,那就出大事了。
也是因为科研的严肃性,大家对于科研类视频里的不规范行为,包容度也更低。
在前段时间变装秀火遍全网的时候,有一些高校也开始拍科研变装秀。

而山东某高校拍的视频,就被骂了。

视频一经发出引热议,网友纷纷讨论:
◆ 实验室穿短裤,是被导师骂少了了吧。
◆ 虽然曾是我母校,但是可以严谨一点,科研人穿实验服露腿是要被导师骂的!
◆ 美女,我不是搞实验的,你穿这样进实验室不合适吧?
这种严肃,其实是件好事,再把科研人的生活科普给普通人的同时,和科研、实验相关的宣传材料应该更谨慎规范,不能把实验室安全娱乐化。
科普任重道远,或许还需要很多人的努力。
—END—高效学习3D视觉三部曲
第一步 加入行业交流群,保持技术的先进性
目前工坊已经建立了3D视觉方向多个社群,包括SLAM、工业3D视觉、自动驾驶方向,细分群包括:[工业方向]三维点云、结构光、机械臂、缺陷检测、三维测量、TOF、相机标定、综合群;[SLAM方向]多传感器融合、ORB-SLAM、激光SLAM、机器人导航、RTK|GPS|UWB等传感器交流群、SLAM综合讨论群;[自动驾驶方向]深度估计、Transformer、毫米波|激光雷达|视觉摄像头传感器讨论群、多传感器标定、自动驾驶综合群等。[三维重建方向]NeRF、colmap、OpenMVS等。除了这些,还有求职、硬件选型、视觉产品落地等交流群。大家可以添加小助理微信: dddvisiona,备注:加群+方向+学校|公司, 小助理会拉你入群。

第二步 加入知识星球,问题及时得到解答
针对3D视觉领域的视频课程(三维重建、三维点云、结构光、手眼标定、相机标定、激光/视觉SLAM、自动驾驶等)、源码分享、知识点汇总、入门进阶学习路线、最新paper分享、疑问解答等进行深耕,更有各类大厂的算法工程人员进行技术指导。与此同时,星球将联合知名企业发布3D视觉相关算法开发岗位以及项目对接信息,打造成集技术与就业、项目对接为一体的铁杆粉丝聚集区,6000+星球成员为创造更好的AI世界共同进步,知识星球入口:「3D视觉从入门到精通」
学习3D视觉核心技术,扫描查看,3天内无条件退款
第三步 系统学习3D视觉,对模块知识体系,深刻理解并运行
如果大家对3D视觉某一个细分方向想系统学习[从理论、代码到实战],推荐3D视觉精品课程学习网址:www.3dcver.com
基础课程:
[1]面向三维视觉算法的C++重要模块精讲:从零基础入门到进阶
工业3D视觉方向课程:
[1](第二期)从零搭建一套结构光3D重建系统[理论+源码+实践]
SLAM方向课程:
[1]如何高效学习基于LeGo-LOAM框架的激光SLAM?
[2]彻底剖析激光-视觉-IMU-GPS融合SLAM算法:理论推导、代码讲解和实战
[3](第二期)彻底搞懂基于LOAM框架的3D激光SLAM:源码剖析到算法优化
[4]彻底搞懂视觉-惯性SLAM:VINS-Fusion原理精讲与源码剖析
[5]彻底剖析室内、室外激光SLAM关键算法和实战(cartographer+LOAM+LIO-SAM)
视觉三维重建
[1]彻底搞透视觉三维重建:原理剖析、代码讲解、及优化改进)
自动驾驶方向课程:
[1] 深度剖析面向自动驾驶领域的车载传感器空间同步(标定)
[2]面向自动驾驶领域目标检测中的视觉Transformer
























 被折叠的 条评论
为什么被折叠?
被折叠的 条评论
为什么被折叠?








